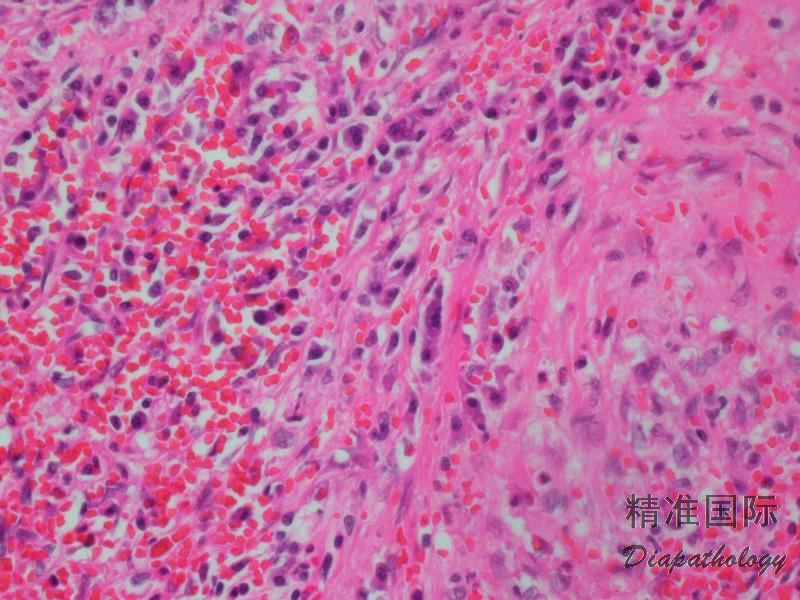
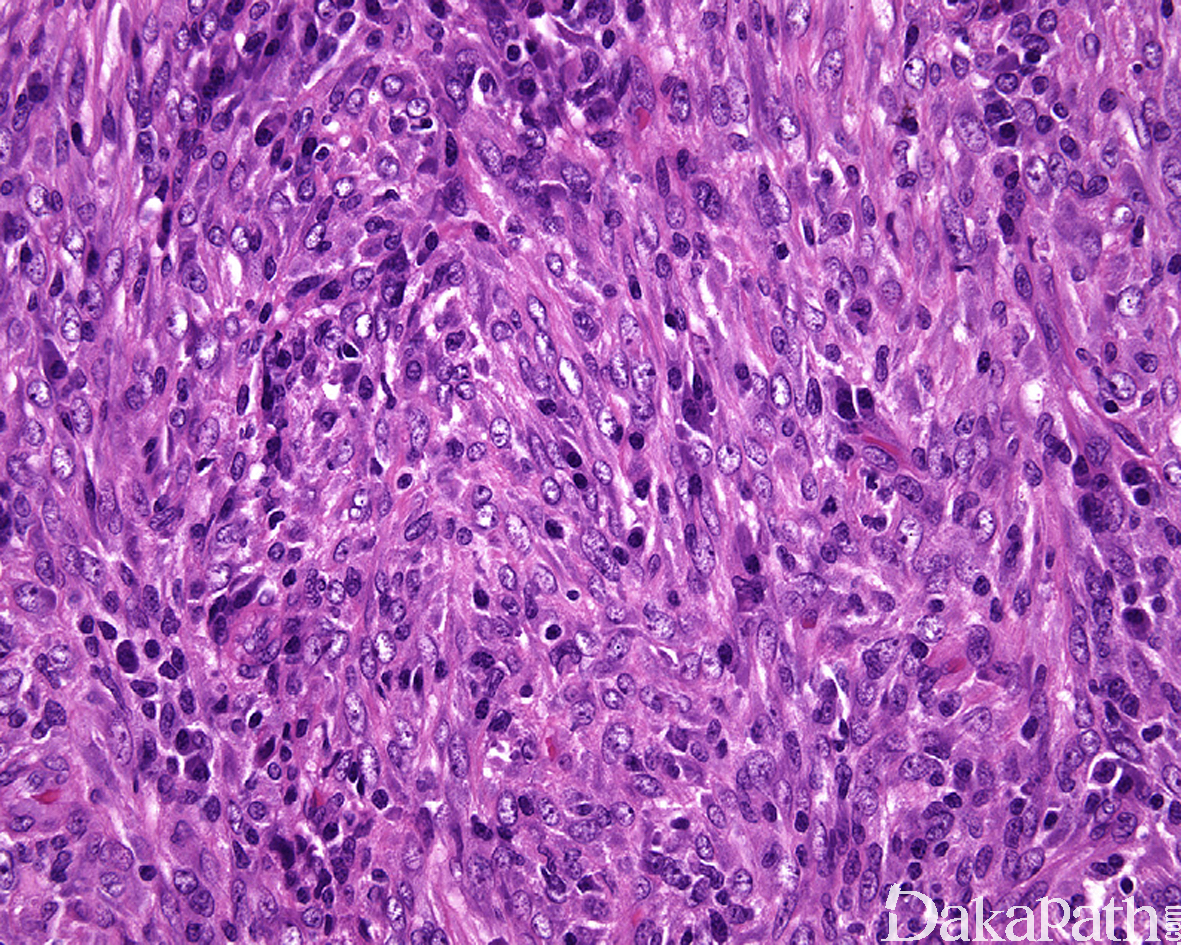
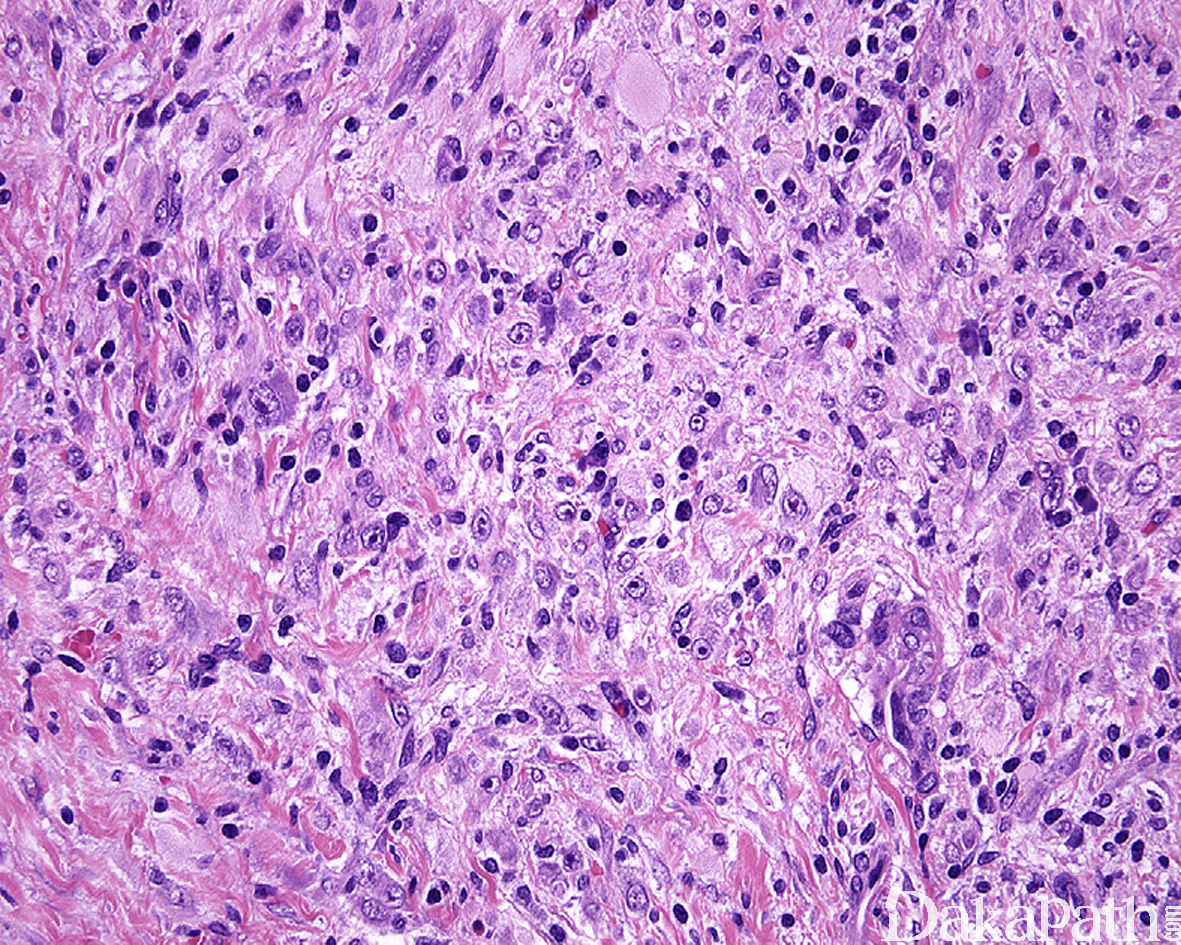

炎性肌纤维母细胞瘤
InfIammatory Myofibroblastic Tumor,IMT
同义词(或曾用名): 浆细胞肉芽肿、炎性假瘤样纤维黏液样肿瘤、炎性假瘤、炎性肌纤维组织细胞性增生、炎性纤维性肉瘤
概述:
是一种独特类型的中间型肌纤维母细胞性肿瘤,由梭形细胞和富于胞浆的神经节细胞样细胞和淋巴浆细胞背景组成,常见 ALK 蛋白过表达和 ALK 基因重排。
发病部位: 最常见的部位是腹腔肠,尤其系膜、大网膜,另见可见于肺、纵膈、泌尿生殖道、女性生殖道和胃肠道器官等,周围软组织相对少见,偶见于头颈部。
诊断要点:
IMT 好发于儿童和年轻成人,40 岁以上发病相对少见;约 15-30%可见系统性症状,包括发热、贫血和体重减轻等,与肿瘤内丰富的炎症浸润和分泌的细胞因子有关;
最常见的部位是腹腔和盆腔,尤其系膜、大网膜,另见可见于肺、纵膈、泌尿生殖道和胃肠道器官等,周围软组织相对少见,偶见于头颈部;
腹腔和盆腔的肿瘤瘤体通常较大,1-20cm, 中位直径 10cm;常见多个肿瘤结节,切面分叶状或多结节状,灰白灰褐,有时可见旋涡状纹理和黏质感;
组织学上,IMT 由比例多少不等的梭形或多角形细胞、纤维/肌纤维母细胞以及淋巴浆细胞混合性组成,部分病例可见嗜酸性粒细胞和中性粒细胞浸润;
梭形细胞可见致密的席纹状或束状排列仅见少量的炎细胞浸润,亦可表现为广泛的炎性背景仅有少数梭形肿瘤细胞;
常见黏液性间质、少细胞区伴有丰富的毛细血管网以及局灶致密的胶原变性等组织学特征,偶见间质钙化;
梭形瘤细胞通常具有卵圆形至伸展的核,小而显著的嗜酸性核仁以及较丰富的双嗜性胞浆,有时候类似于萎缩的横纹肌细胞或神经节细胞;
根据病变时限的长短,IMT 可显示一系列谱系的形态学改变包括相对温和和少细胞的硬化性病变至更富于细胞和伴有非典型性的病变,有时可以某种形态学为主,亦可同时出现在同一病变内;
核分裂象多少不等,但通常较少,罕见坏死;
具有较多神经节细胞样肿瘤细胞的 IMT 相对较可能显示侵袭性的生物学行为;
有时可见血管浸润,但无预后意义。

免疫组织化学染色:
半数以上的病例中肿瘤细胞表达 ALK 蛋白,多数病例表达 SMA 和 MSA,部分表达 desmin, 30%左边可表达角蛋白 AE1/3 和 Cam5.2,不表达 S100 蛋白、myogenin、MyoD1. CD117. CD34. CD21. CD35 等标志物。
分子标记:
半数以上存在 ALK 基因重排(伴侣基因包括 TMP3, TMP4, CLTC, CARS, ATIC, RANBP2, SEC31L1,PPFIBPI 等),少数可见 ROS1. PDGFRB, RET,NTRK3 等基因重排,EBER 阴性
鉴别诊断:
- 炎症性恶性纤维组织细胞瘤(未分化多形性肉瘤) :多发生于成年人,好发于腹膜后。由畸形的多形性细胞组成,有时瘤细胞可被大量的黄色瘤细胞和炎症细胞所掩盖,免疫组化染色 ALK 阴性,SMA、desmin 常阴性。
2. 胃肠道炎性纤维性息肉 :体积较小,且多位于黏膜浅表,或呈息肉状,或为溃疡性病变。背景常呈黏液样,含有较多增生的血管,炎症细胞成分较杂,以嗜酸性粒细胞多见,免疫组织化学染色 CD34 常阳性,ALK(-)。
3. 硬化性肠系膜炎/后腹膜盆腔炎/纵隔炎 :多见于中老年人,病变周界不清,主要由增生的纤维组织组成,间质硬化比较明显,可见多少不等的慢性炎症细胞浸润。
4. 结外滤泡树突状细胞肉瘤 :肝或脾滤泡树突肉瘤中的瘤细胞表达 CD21. CD23. CD35 和 clusterin,而 actin 或 desmin 等为阴性。肝滤泡树突肉瘤 EBER.原位杂交多呈阳性。
- 炎症性**平滑肌肉瘤** :细胞丰富嗜酸性,异型性明显,核常呈雪茄样,核分裂像多见,并可见病理性核分裂。瘤细胞常呈长的束状排列,间质内可见较多量淋巴细胞浸润,免疫组化染色可表达 ALK,但瘤细胞胞浆明显更嗜酸性和原纤维状、核顿圆而非纺锤状,无 ALK 基因重排可与 IMT 鉴别。
6 .结节性筋膜炎: 常发生于四肢,病变通常较小,快速生长,黏液性背景较丰富,炎症较 IMT 稀疏,以组织培养样细胞为主,罕见神经节细胞样细胞,USP6 基因重排阳性,ALK(-)。
7. 韧带样纤维瘤病: 梭形细胞长束状交叉排列,炎细胞一般较少,免疫组化染色 ALK(-), β-catenin 大多数病例核阳性。
8. 胃肠道间质瘤 :罕见神经节细胞样细胞和丰富炎细胞浸润,CD34. CD117. DOG1 常阳性,ALK(-);
炎性肌纤维母细胞瘤样去分化脂肪肉瘤:仔细取材通常可见高分化脂肪肉瘤成分,免疫组化染色弥漫表达 P16 和 CDK4 以及 MDM2,存在 MDM2 基因扩增;
胚胎性横纹肌肉瘤:罕见丰富的淋巴浆细胞浸润,免疫组化染色可表达 ALK 但无 ALK 基因重排,但表达更特异的横纹肌标志物 myoD1 和 myogenin 可资鉴别;
IgG4 相关性疾病:中老年人发病为主,组织学上以丰富的淋巴浆细胞浸润和席纹状纤维化以及闭塞性静脉炎为主,无神经节细胞样细胞,背景中含有较多的 IgG4 阳性的浆细胞,IgG4/IgG 通常> 40%。
治疗:
局部广泛切除,复发和转移的病例可用 ALK 络氨酸激酶抑制剂治疗
参考文献:
Alassiri AH, Ali RH, Shen Y, et al. ETV6-NTRK3 is expressed in a subset of ALK-negative inflammatory myofibroblastic tumors. Am J Surg Pathol. 2016;40:1051–1061. Antonescu CR, Suurmeijer AJ, Zhang L, et al. Molecular characterization of inflammatory myofibroblastic tumors with frequent ALK and ROS1 gene fusions and rare novel RET rearrangement. Am J Surg Pathol. 2015;39:957–967
Gleason B . Inflammatory myofibroblastic tumors : where are we now?[J]. Journal of Clinical Pathology, 2008, 61(4):428.
